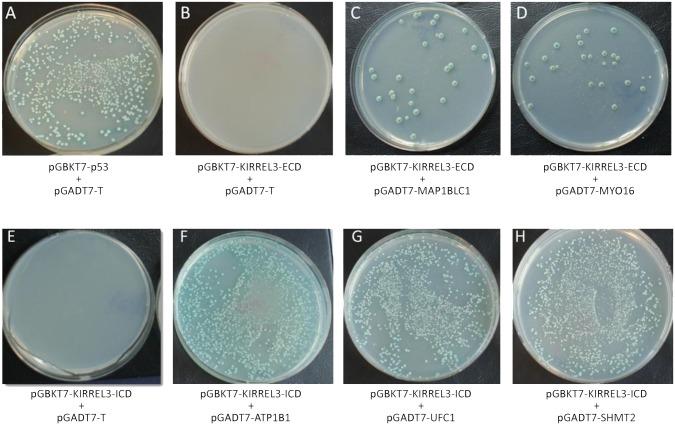

与自闭症和智力残疾相关的KIRREL3与神经元蛋白MAP1B和MYO16相互作用,在神经发育中具有潜在作用。
Autism and Intellectual Disability-Associated KIRREL3 Interacts with Neuronal Proteins MAP1B and MYO16 with Potential Roles in Neurodevelopment.
作者信息
Liu Ying F, Sowell Sarah M, Luo Yue, Chaubey Alka, Cameron Richard S, Kim Hyung-Goo, Srivastava Anand K
机构信息
J.C. Self Research Institute of Human Genetics, Greenwood Genetic Center, Greenwood, South Carolina, United States of America.
Department of Medicine, Georgia Regents University, Augusta, Georgia, United States of America.
出版信息
PLoS One. 2015 Apr 22;10(4):e0123106. doi: 10.1371/journal.pone.0123106. eCollection 2015.
Cell-adhesion molecules of the immunoglobulin superfamily play critical roles in brain development, as well as in maintaining synaptic plasticity, the dysfunction of which is known to cause cognitive impairment. Recently dysfunction of KIRREL3, a synaptic molecule of the immunoglobulin superfamily, has been implicated in several neurodevelopmental conditions including intellectual disability, autism spectrum disorder, and in the neurocognitive delay associated with Jacobsen syndrome. However, the molecular mechanisms of its physiological actions remain largely unknown. Using a yeast two-hybrid screen, we found that the KIRREL3 extracellular domain interacts with brain expressed proteins MAP1B and MYO16 and its intracellular domain can potentially interact with ATP1B1, UFC1, and SHMT2. The interactions were confirmed by co-immunoprecipitation and colocalization analyses of proteins expressed in human embryonic kidney cells, mouse neuronal cells, and rat primary neuronal cells. Furthermore, we show KIRREL3 colocalization with the marker for the Golgi apparatus and synaptic vesicles. Previously, we have shown that KIRREL3 interacts with the X-linked intellectual disability associated synaptic scaffolding protein CASK through its cytoplasmic domain. In addition, we found a genomic deletion encompassing MAP1B in one patient with intellectual disability, microcephaly and seizures and deletions encompassing MYO16 in two unrelated patients with intellectual disability, autism and microcephaly. MAP1B has been previously implicated in synaptogenesis and is involved in the development of the actin-based membrane skeleton. MYO16 is expressed in hippocampal neurons and also indirectly affects actin cytoskeleton through its interaction with WAVE1 complex. We speculate KIRREL3 interacting proteins are potential candidates for intellectual disability and autism spectrum disorder. Moreover, our findings provide further insight into understanding the molecular mechanisms underlying the physiological action of KIRREL3 and its role in neurodevelopment.
免疫球蛋白超家族的细胞黏附分子在大脑发育以及维持突触可塑性方面发挥着关键作用,已知其功能障碍会导致认知障碍。最近,免疫球蛋白超家族的突触分子KIRREL3的功能障碍与多种神经发育疾病有关,包括智力残疾、自闭症谱系障碍以及与雅各布森综合征相关的神经认知延迟。然而,其生理作用的分子机制在很大程度上仍不清楚。通过酵母双杂交筛选,我们发现KIRREL3细胞外结构域与大脑表达的蛋白MAP1B和MYO16相互作用,其细胞内结构域可能与ATP1B1、UFC1和SHMT2相互作用。通过对人胚肾细胞、小鼠神经元细胞和大鼠原代神经元细胞中表达的蛋白进行共免疫沉淀和共定位分析,证实了这些相互作用。此外,我们显示KIRREL3与高尔基体和突触小泡的标志物共定位。此前,我们已经表明KIRREL3通过其细胞质结构域与X连锁智力残疾相关的突触支架蛋白CASK相互作用。此外,我们在一名患有智力残疾、小头畸形和癫痫的患者中发现了一个包含MAP1B的基因组缺失,在两名患有智力残疾、自闭症和小头畸形的无关患者中发现了包含MYO16的缺失。MAP1B此前已被证明与突触发生有关,并参与基于肌动蛋白的膜骨架的发育。MYO16在海马神经元中表达,也通过与WAVE1复合体的相互作用间接影响肌动蛋白细胞骨架。我们推测KIRREL3相互作用蛋白是智力残疾和自闭症谱系障碍的潜在候选者。此外,我们的发现为理解KIRREL3生理作用的分子机制及其在神经发育中的作用提供了进一步的见解。